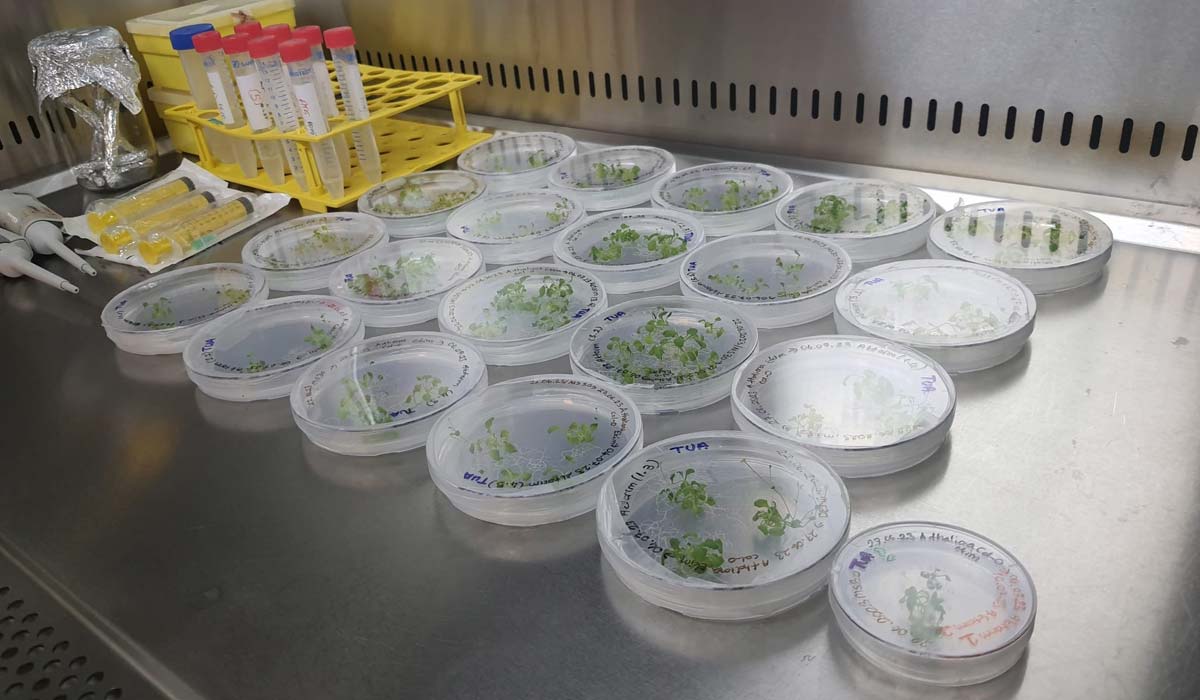
Эксперименты Турции во время миссии Ax-3

Турецкий исследовательский портфель, возглавляемый Исследовательским институтом космических технологий Научного и технологического исследовательского совета Турции (TÜBITAK UZAY) и Турецким космическим агентством (TUA), расширяется с помощью передовых технологических разработок нового оборудования и возможностей для дальнейшего продвижения целей Турции как космической державы.
Во время миссии Axiom Mission 3, запуск которой планируется на первый квартал 2024 года, турецкий астронавт Альпер Гезерави проведет ряд исследований на борту Международной космической станции.
CRISPR GEM – Extremophyte
Исследование эффективности редактирования генов CRISPR у растений в условиях микрогравитации (GEM) и реакции на солевой стресс модели экстремального галофита Schrenkiella parvula в космической среде.

CRISPR — это новаторский научный метод генетического редактирования, который можно использовать для увеличения, уменьшения, вставки или удаления генов из организмов. В этом проекте, спонсируемом TÜBİTAK UZAY, исследователи будут исследовать с помощью техники CRISPR подавление трех генов, участвующих в реакции на стресс Arabidopsis thaliana (кресс-салат, член семейства горчичных). Вторая часть исследования будет оценивать устойчивость к солевому стрессу двух растений — одного чувствительного к соли и одного толерантного к соли — которые будут проращиваться и выращиваться на Международной космической станции (МКС). Эта работа основана на предыдущих исследованиях микрогравитации, показывающих, как микрогравитация влияет на рост, движение и генетику растений. Проект также может предоставить ценную информацию об адаптации растений к экстремальным условиям и помочь создать более устойчивые сельскохозяйственные культуры.
Vokalkord
Эксперимент «Вокалкорд» будет сосредоточен на разработке системы искусственного интеллекта, которая работает на мобильных устройствах и позволяет обнаруживать более 70 типов заболеваний, включая инфекционные заболевания, заболевания голоса и голосовых связок и даже сердечно-сосудистые заболевания, путем анализа звуков дыхания, фонации и кашля. Испытание инструмента в условиях микрогравитации позволит исследователям продолжить проверку системы как простой в использовании телемедицинской системы, которую в будущем можно будет использовать для мониторинга здоровья участников космических полетов.
UYNA
Инновационные исследования новых космических сплавов
Эксперимент UYNA будет исследовать новые сплавы со средней (MEA) и высокой (HEA) энтропией. Эти типы металлических сплавов характеризуются высокой прочностью, вязкостью и устойчивостью к коррозии и представляют интерес для потенциального применения во многих отраслях промышленности, включая космическую, авиационную, автомобильную, энергетическую и медицинскую. Данные этого эксперимента помогут улучшить понимание формирования и свойств сплавов MEA/HEA, что может привести к разработке новых и улучшенных материалов для различных применений.
gMETAL
Влияние микрогравитации на динамику металлических частиц в жидкостях
Проект gMETAL будет исследовать, как микрогравитация влияет на смешивание твердых частиц с газом (образование двухфазной смеси) в замкнутой среде. Этот проект важен для понимания того, как частицы металла и окисляющий газ могут вступать в реакцию в камере сгорания для эффективного сгорания и максимального выделения тепла. Применение этого исследования включает разработку технологий производства энергии с нулевым выбросом углерода на Земле, а также разработку двигательных систем или производства энергии на Марсе.
MESSAGE
Генетические исследования, связанные с микрогравитацией
В этом исследовании будут оцениваться связанные с микрогравитацией изменения в экспрессии генов в Т-клетках иммунной системы человека, собранных у космонавта. После полета проект будет использовать технологии редактирования генов CRISPR, чтобы отключить гены в Т-клетках, активность которых, как выяснилось, активировалась во время космических путешествий. Исследователи также будут стремиться вызвать ответ иммунных клеток с помощью наблюдаемых изменений генов, связанных с микрогравитацией, используя устройство акустической левитации на земле, чтобы имитировать микрогравитацию и исследовать клеточные изменения в пролиферации, выживании и реакциях на стресс. Благодаря лучшему пониманию реакции иммунной системы на стресс микрогравитации этот проект направлен на выявление потенциальных астронавтов-исследователей, которые могут больше подходить для космических полетов из-за устойчивости их иммунной системы.
Metabolom
Анализ изменений метаболома/транскриптома космонавтов в космическом полете
Космический полет может стать стрессовым опытом, поскольку человеческое тело адаптируется к изменениям в условиях микрогравитации, таким как физические нагрузки, изменения в питании и недостаток сна. Физиологические изменения можно отслеживать путем профилирования изменений в экспрессии генов (геномика), экспрессии белков (протеомика) или метаболитов (метаболомика). Лучшее понимание индивидуальной реакции космонавта на космический полет может помочь разработать персонализированные процедуры противодействия, которые могут оптимизировать безопасность и работоспособность каждого космонавта.
Этот проект направлен на сбор данных во время миссии Ax-3, чтобы лучше понять влияние кратковременных космических путешествий на метаболизм человека, регуляцию иммунной системы и связанные с ними гены в условиях микрогравитационного стресса. Этот проект будет информировать турецких исследователей, работающих в области гравитационной физиологии, авиации и космической медицины, о передовых методах ухода за космонавтами в рамках развивающейся национальной космической программы Турции.
Pranet-Algalspace
Экстракт прополиса — это натуральный продукт пчел, называемый «пчелиный клей», используемый для строительства и содержания ульев, известный своими антиоксидантными, противовоспалительными и противомикробными свойствами. Первая часть этого исследовательского проекта, получившего название «Пранет», представляет собой STEM-проект, возглавляемый 13-14-летними учениками, целью которого является изучение влияния экстракта прополиса на бактерии в условиях микрогравитации. Если эксперименты докажут, что экстракт прополиса может проявлять антимикробные свойства в космосе, это может открыть возможности для будущих исследований новых чистящих средств на основе натуральных продуктов для будущих космических полетов.
Вторая часть этого проекта, получившая название Algalspace, включает в себя проведение сравнительного исследования выращивания микроводорослей Антарктики и умеренного пояса в условиях космоса. Собранная информация поможет внести ценный вклад в исследования, направленные на создание устойчивых биорегенеративных систем жизнеобеспечения для космических миссий.

UzMan
Микроводорослевые системы жизнеобеспечения для космических полетов
Водоросли обладают многими свойствами, которые делают их идеальными организмами для поддержки людей во время длительных космических полетов. Вариант использования водорослей включает в себя использование в качестве источника питания в меню космонавтов, удаление углекислого газа и производство кислорода для систем экологического контроля космического корабля, помощь в регулировании температуры космического корабля, переработку определенных отходов и даже действие в качестве источника топлива. Данные, полученные в результате этого эксперимента, будут использоваться для продвижения разработки систем жизнеобеспечения микроводорослей для космических миссий и могут повлиять на конструкцию будущих систем улавливания углекислого газа, преобразования кислорода, систем очистки сточных вод, а также предоставить варианты удобрений для других сельскохозяйственных культур, выращиваемых в космосе.